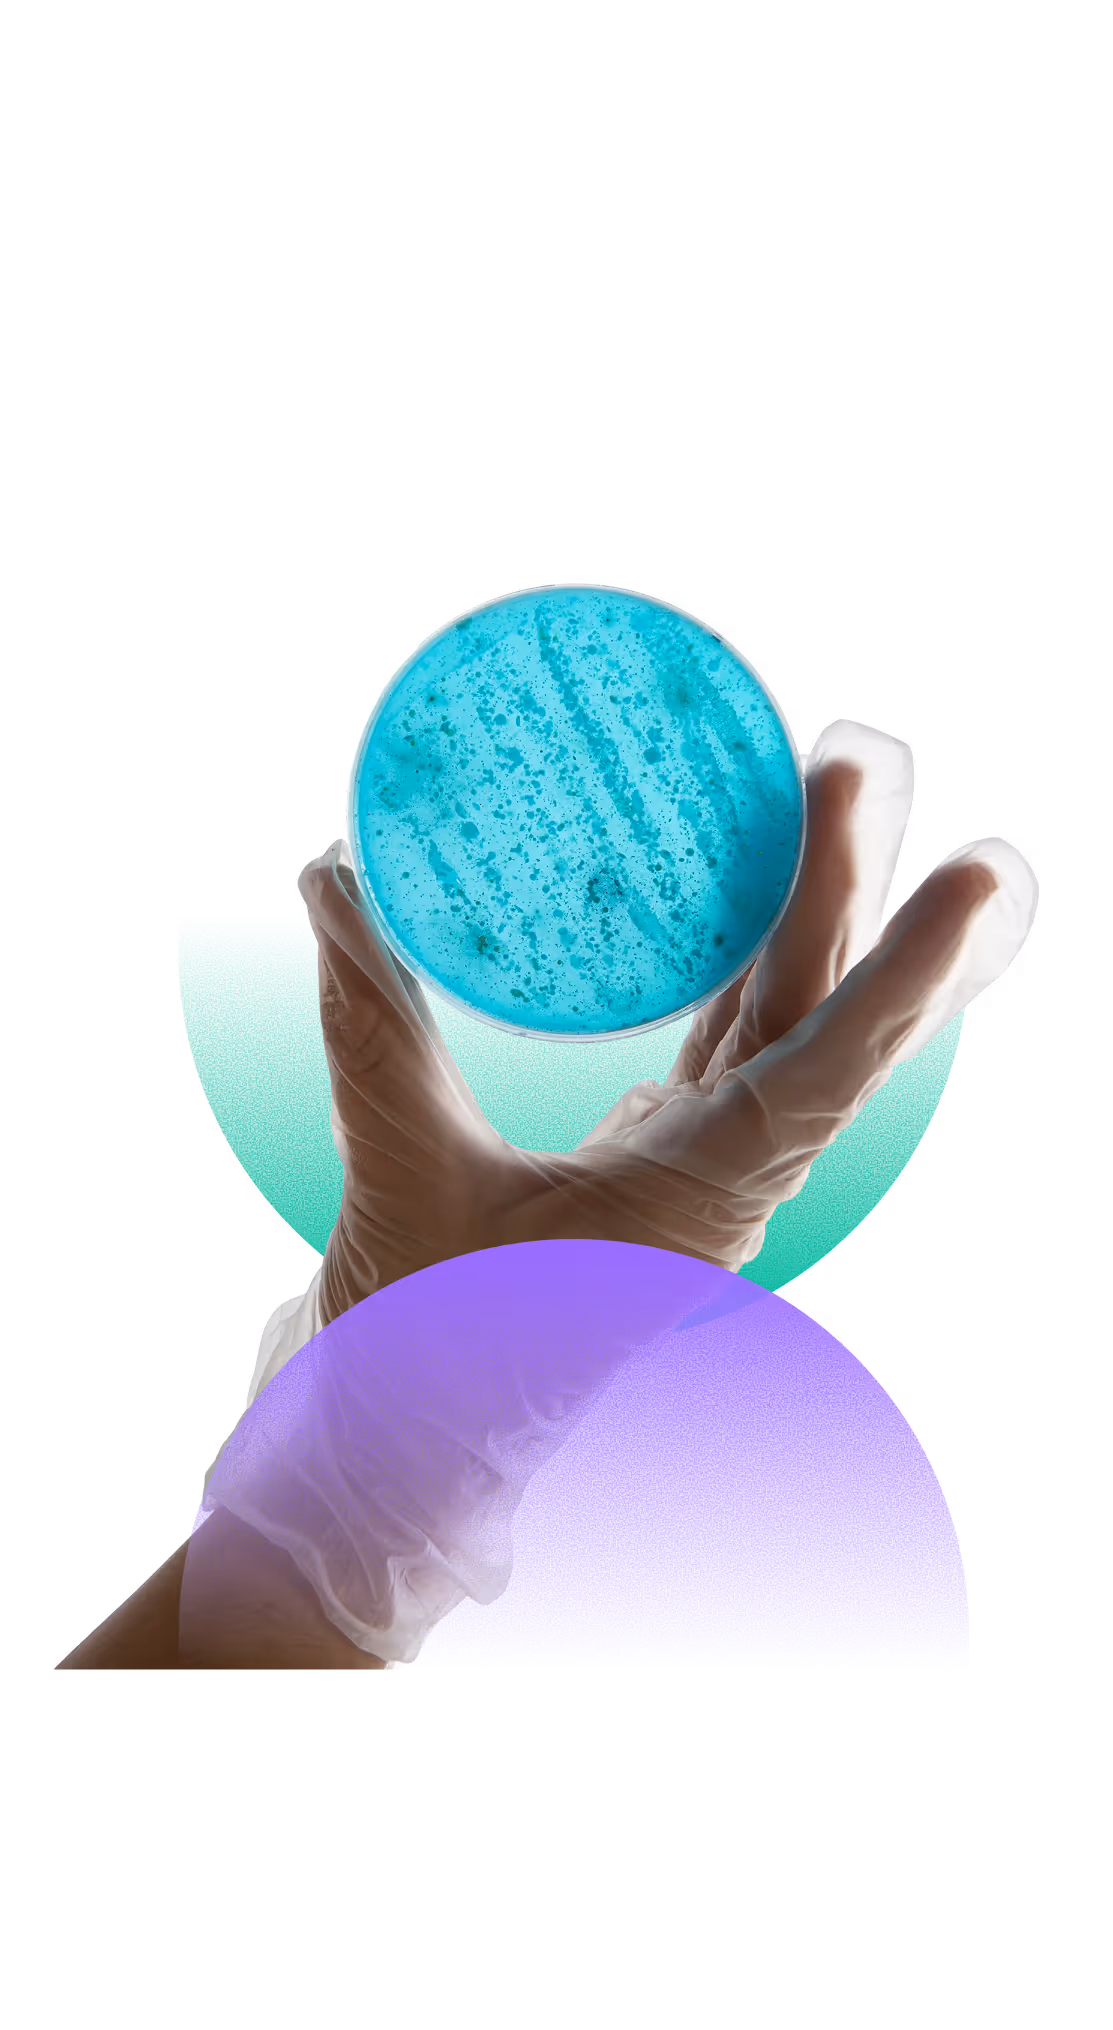
Hand wearing a transparent glove holding a petri dish with blue bacterial culture.

Impulsamos la trazabilidad farmacéutica a nivel global.
En Verifarma desarrollamos soluciones tecnológicas que ayudan a laboratorios, distribuidores y autoridades sanitarias a cumplir regulaciones, garantizar la trazabilidad y proteger al paciente en cada mercado.

+16 años de experiencia en la industria farmacéutica
Verifarma nació para acompañar a la industria farmacéutica con soluciones tecnológicas confiables, enfocadas en la seguridad del paciente y el cumplimiento normativo.



Inicios de Verifarma en IAE Business School

Lanzamos Verifarma Track & Trace

- ANMAT – Resolución 435/2011.
- Inauguramos el reporte a ANMAT 70 días antes.
- 700 empresas y más de 400 laboratorios trazan con Verifarma.

SEDRONAR / RENPRE – Resolución 900/12
- Precursores químicos
- Productos veterinarios

- Premio Fundación Exportar
- Formamos parte del grupo OPEN-SCS
- Lanzamos Edifarma

- Reglamentación de trazabilidad en Europa
- Verifarma cumple en tiempo y forma
Descubra nuestra Suite de Calidad Life Science
En Verifarma desarrollamos soluciones tecnológicas integrales para la life science y de la salud, acompañando a las organizaciones en todo el ciclo de vida del medicamento: desde la calidad y el cumplimiento regulatorio, hasta la trazabilidad y la gestión del negocio.
Track & Trace

LIMS
Sistema de Gestión de Laboratorio

RIMS
Sistema de Asuntos Regulatorios




Nuestras Oficinas




Nuestra forma de trabajar
Creemos que la tecnología debe estar al servicio de la salud y la confianza. Cada proyecto se basa en cuatro pilares que guían nuestro trabajo:
Desarrollamos soluciones tecnológicas seguras, pensadas para acompañar la evolución del sector farmacéutico.
Trabajamos de forma cercana con cada cliente, brindando acompañamiento, soporte y validación continua.
Protegemos la integridad y confidencialidad de la información en cada etapa del sistema.
Aseguramos la adecuación a regulaciones y estándares internacionales en todos los mercados donde operamos.
Calidad, seguridad y estándares internacionales
Verifarma Track&Trace opera bajo los principales estándares de gobernanza digital, integridad de datos y serialización internacional.
GS1 – Estándares globales de identificación
ISO 9001 – Gestión de la calidad
ISO 27001 – Seguridad de la información
Validable según GAMP 5
GMP
El equipo detrás de la innovación












¿Quiere saber más sobre Verifarma?
Conozca cómo nuestras soluciones pueden adaptarse a sus procesos y requerimientos regulatorios. Nuestro equipo lo acompañará en una demostración personalizada.

